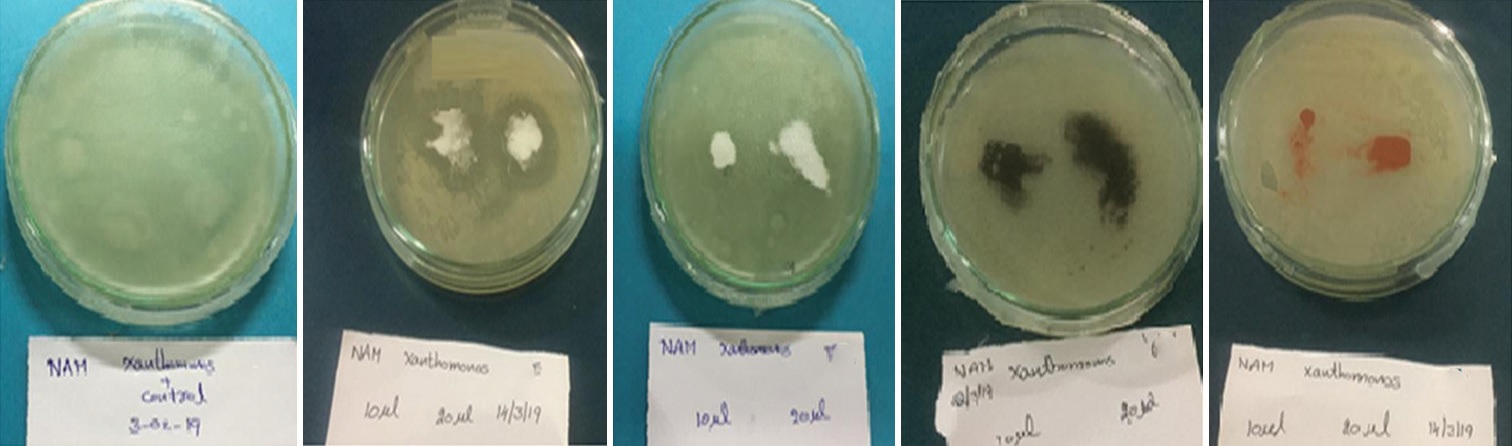
Article Image

Issue Details

September, 2021
Volume: 9, Issue: 3
📅 Published on: 05 Sep 2021
Articles in this Issue
Annulation of Internal Alkyne toward Synthesis of Selective E-Benzofulvene and Mechanistic Study using Density Function Theory Calculation
Authors: Shubhendu Dhara*, Anuvab Das, Dhiraj Das, Rajesh Koner
DOI: 10.22607/IJACS.2021.903002 | Pages: 105-110

Application of the Radiometric Method of Uranium, Thorium, and Potassium in the Cabo Frio Region, Brazil
Authors: Igor de Almeida Bichara Calanca, Caio Martins Ramos, Letcia Kizuka Pereira, Ludmila Ravane Santos da Silva, Hans Schmidt Santos, Felipe Venncio Barbosa de Freitas, Christine Barros de S
DOI: 10.22607/IJACS.2021.903003 | Pages: 111-118

Synthesis, Molecular Docking, Antibacterial, and Antifungal Studies of Co (II) and Cu (II) Complexes of N1, N2-Bis((1,3-Diphenyl-1H-pyrazol-4-yl) Methylene)Ethane-1,2-Diamine
Authors: P. V. Sandhya, K. R. Haridas*
DOI: 10.22607/IJACS.2021.903005 | Pages: 125-131

Radiometric Characteristics of the Lagoa Real Uraniferous Province, Brazil
Authors: T. C. R. Nascimento, M. J. S. F. dos Santos, A. D. Vieira, B. P. Muniz, H. S. Santos, F. B. V. Freitas, C. M. dos Santos
DOI: 10.22607/IJACS.2021.903006 | Pages: 132-142

Synthesis, Structural, Textural, Optical, Photoluminescence, and Magnetic Properties of Co0.21Cu0.79O Nanoparticles Fabricated through [Co0.21Cu0.79(Cre)2(N2H4)2] Precursor. Evaluation of In Vitro Antioxidant and Anticancer Activities
Authors: N. Anjuthaprabha, R. Manimekalai
DOI: 10.22607/IJACS.2021.903007 | Pages: 143-151

Synthesis and Characterization of Sodium Carboxymethyl Cellulose Graft Copolymers with 2-Acrylamido-2-methyl-1-propanesulfonic Acid and Sodium 4-Vinylbenzene Sulfonate
Authors: R. Vijitha, K. Nagaraja, K. S. V. Krishna Rao*
DOI: 10.22607/IJACS.2021.903008 | Pages: 152-157

Removal of Rhodamine 6G dye from Water Solution by Alt-maleic anhydride-styrene Copolymer, Cross-linked with Glycerin
Authors: Oktay Akperov*, Fatima Kamranzadeh, Elchin Akperov, Mirheydar Abbasov, Leyla Durmazucar
DOI: 10.22607/IJACS.2021.903011 | Pages: 166-173

Electrical Conductivity and Organic Vapour Sensing Properties of Novel Nanocomposite Comprising Polypyrrole, Tin Oxide Nanoparticles and Single-Walled Carbon Nanotubes
Authors: Jassim Hosny Al Dalaeen, Ahmad Husain*, Mohd Urooj Shariq, Anees Ahmad
DOI: 10.22607/IJACS.2021.903012 | Pages: 174-180

In Vitro, Characterization, and DNA-binding Studies of Synthesized Gold Nanoparticles using Orange (Citrus sinensis) Peels Extract
Authors: Kasigari Chandra Rekha, Gugulothu Yaku, M. Prashanthi, Umesh Kumar Utkoor*
DOI: 10.22607/IJACS.2021.903016 | Pages: 205-209

Rapid and Spontaneous Synthesis of Schiff Bases Catalyzed by Sulfuric Acid under Environmentally Benign Condition
Authors: Noorunnisa Begum, Sadiya Mustaq, Syeda Sameena Aziz*, Mohammed Arifuddin*
DOI: 10.22607/IJACS.2021.903019 | Pages: 218-225

Ultrasonically Assisted Thiocyanation of Aromatic and Heteroaromatic Compounds Using Silica-Supported Bronsted Acids (HClO4-SiO2 and KHSO4-SiO2) as Reusable Catalysts
Authors: Vijay Shekar Pulusu, K. C. Rajanna*, U. Umesh Kumar, M. Anil Kmar, Yaku Guguloth, Yadagiri Pulusu
DOI: 10.22607/IJACS.2021.903020 | Pages: 226-235

Potential Ecological Risk of Heavy Metals in Sediments from the Ivory Coastal Areas (Toukouzou Hozalem-Assinie)
Authors: Laure Emma Oura, Affoué́ Tindo Sylvie Konan, Konan Edmond Kouassi, Horo Koné*, Kouakou Adjoumani Rodrigue, Kouassi Benjamin Yao
DOI: 10.22607/IJACS.2021.903022 | Pages: 243-249